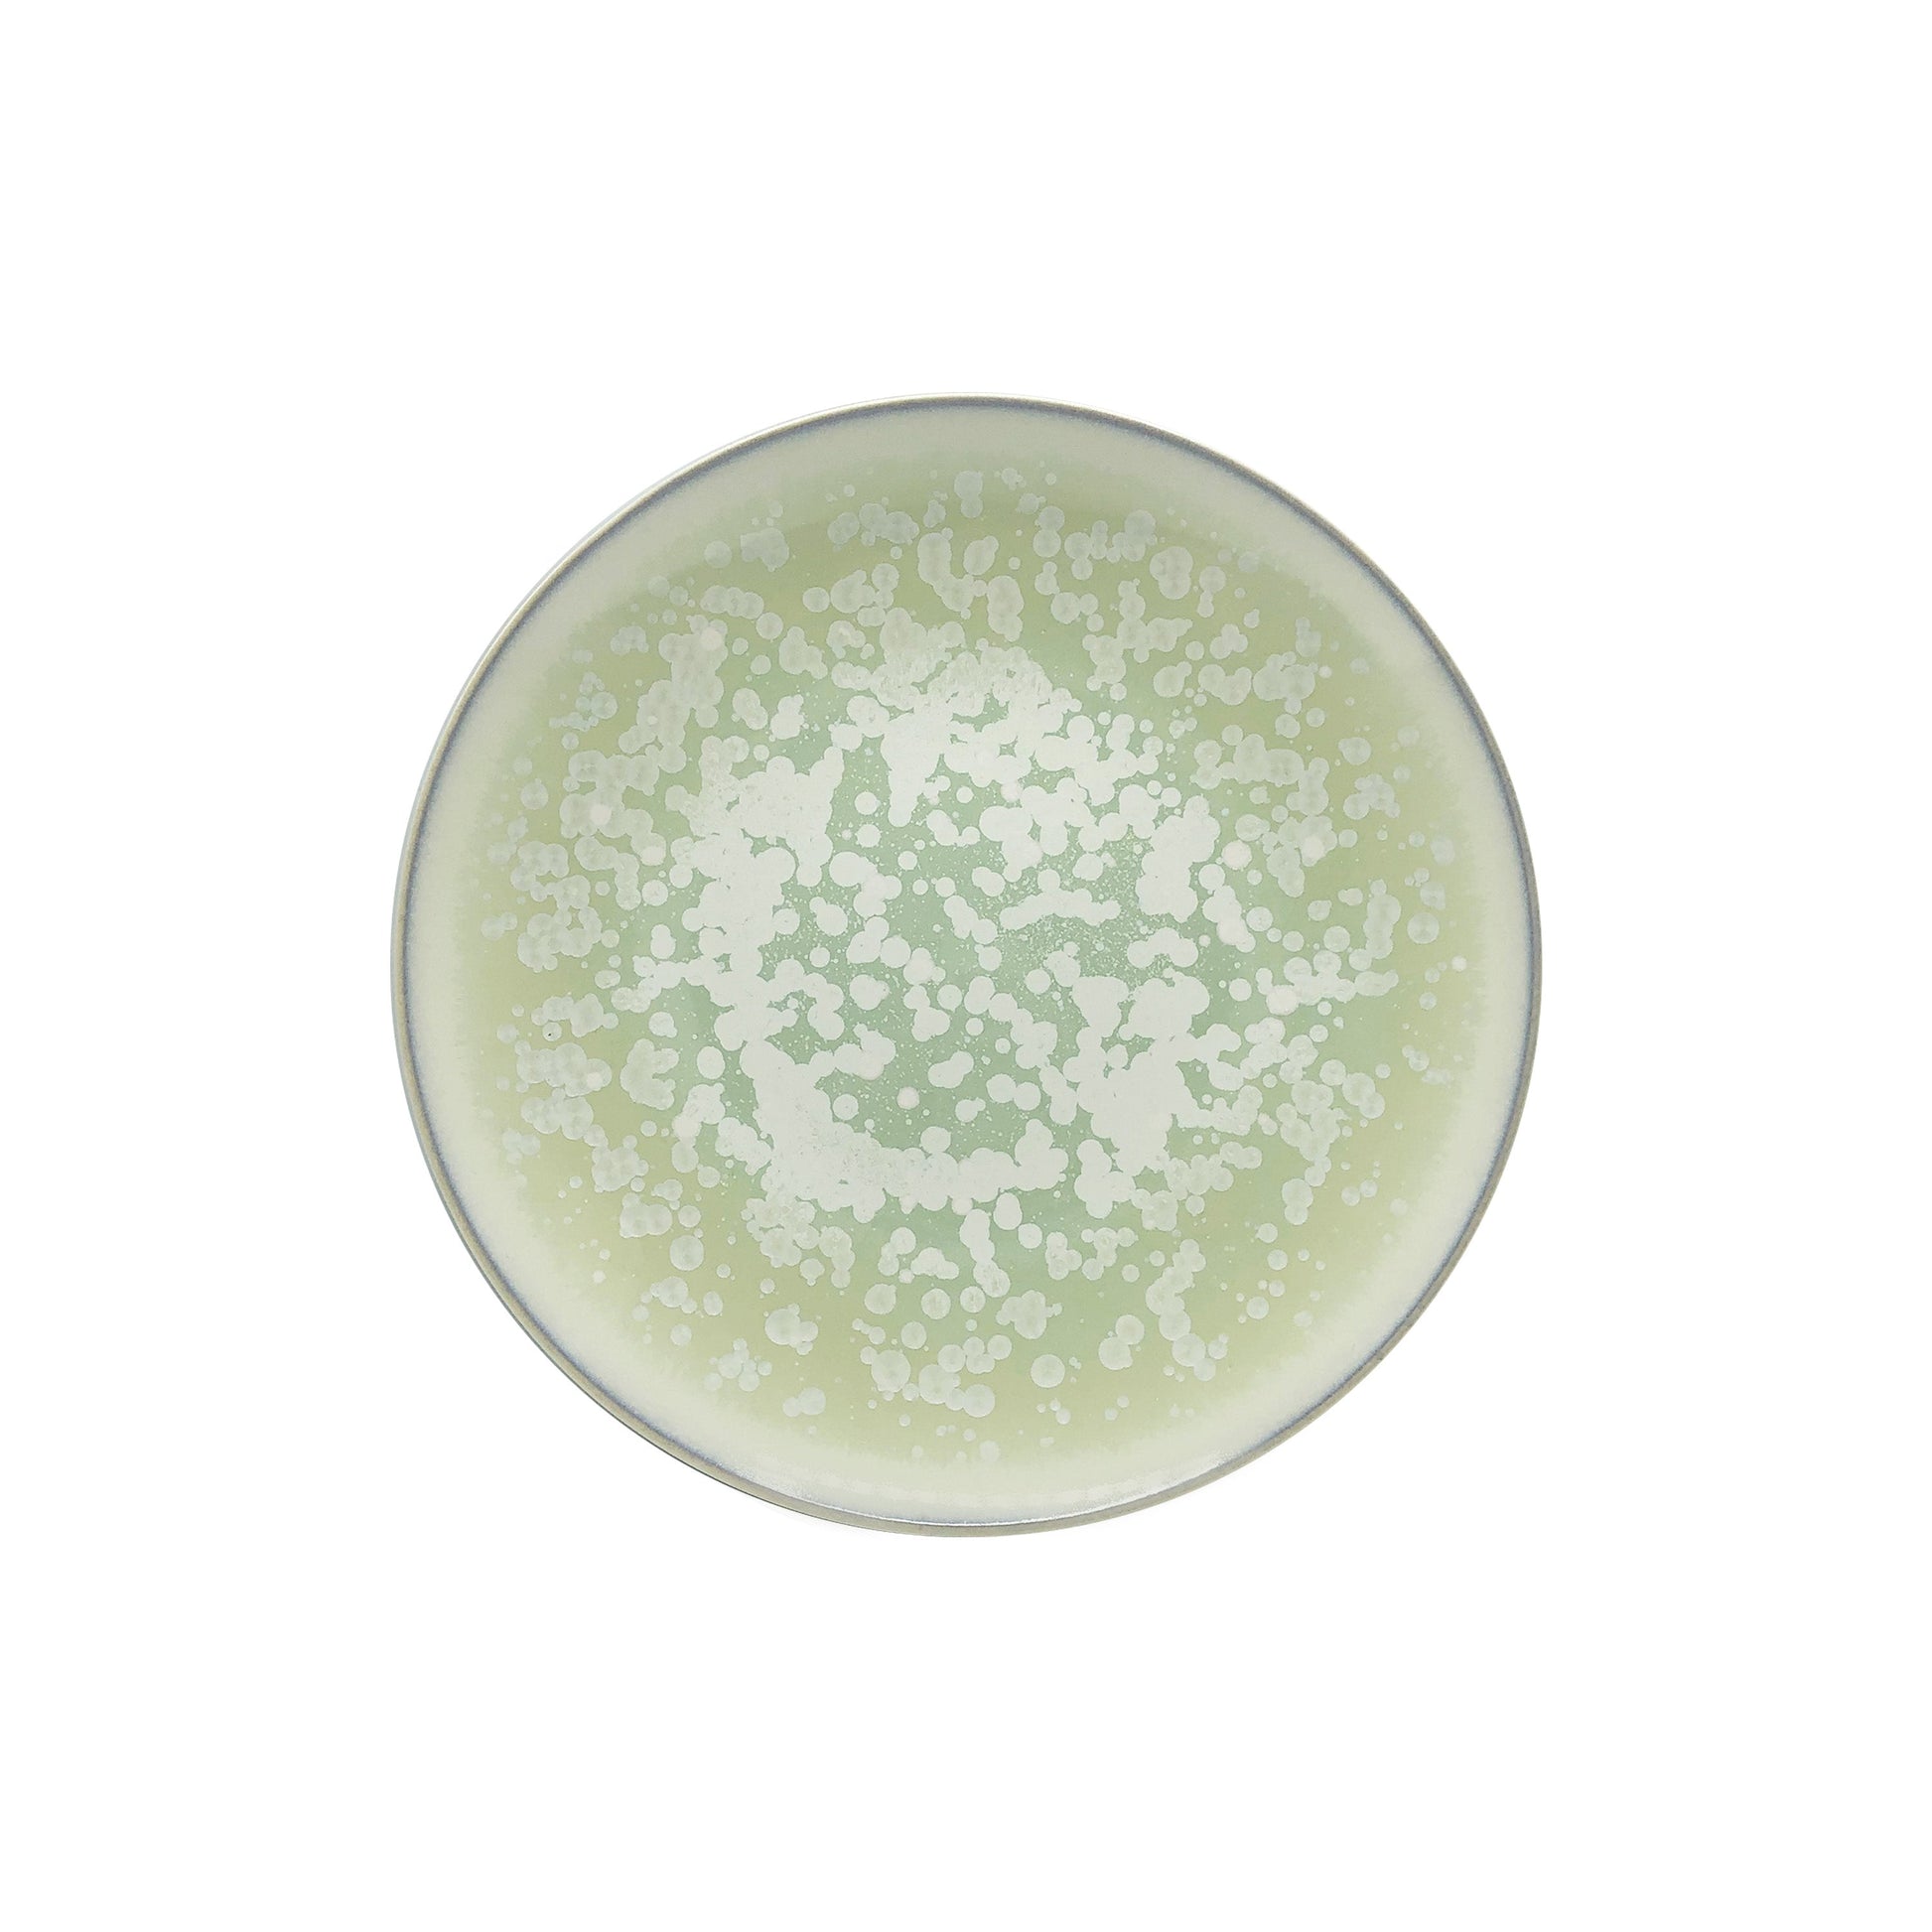
JL Coquet  SONG Amande - Assiette ? dessert, Agora 8.27 Inch SKU: AGO1028SGAMCREM000

1
/
of
1
JL Coquet
JL Coquet SONG Amande - Dessert plate, Agora 8.27 Inch SKU: AGO1028SGAMCREM000
JL Coquet SONG Amande - Dessert plate, Agora 8.27 Inch SKU: AGO1028SGAMCREM000
Regular price
$151.52 USD
Regular price
Sale price
$151.52 USD
Quantity
Couldn't load pickup availability
Plate used for the presentation of your starters or desserts.
Shape: Agora
Decoration Song Almond
Share